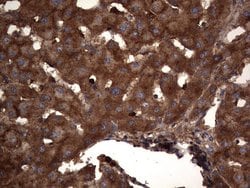
CEA (CEACAM5) Monoclonal Antibody (OTI1C2), TrueMAB , OriGene 100 &mu;L;

missing translation for 'onlineSavingsMsg'
Learn More
Learn More
CEA (CEACAM5) Monoclonal Antibody (OTI1C2), TrueMAB™, OriGene
Mouse Monoclonal Antibody
Marca: Origene Technologies TA803415

Questo articolo non è restituibile.
Consulta la politica di reso
Descrizione
CEA (Carcino Embryonic Antigen, CD66e) is synthesized during development in the fetal gut, and re-expressed in increased amounts in intestinal carcinomas and several other tumors. CEA is a member of carcinoembryonic antigens, immunoglobulin supergene family and consists of a single N domain (structural homology to the immunoglobulin variable) and six immunoglobulin constant-like A (A1, A2, A3) and B domains (B1, B2, B3). Antibodies to CEA are useful in identifying the origin of various metastatic adenocarcinomas and in distinguishing pulmonary adenocarcinomas (60 to 70% are CEA+) from pleural mesotheliomas (rarely or weakly CEA+). CEA is a member of a large family of glycoproteins, a useful tumor marker for adenocarcinoma, and found in adenocarcinomas of endodermally derived digestive system epithelium and fetal colon. Two subgroups of the CEA family, the CEA cell adhesion molecules and the pregcy-specific glycoproteins, are located within a 1.2 Mb cluster on the long arm of chromosome 19. Eleven pseudogenes of the CEA cell adhesion molecule subgroup are also found in the cluster. CEA was originally described in bile ducts of liver as biliary glycoprotein. Subsequently, CEA was found to be a cell-cell adhesion molecule detected on leukocytes, epithelia, and endothelia. The encoded protein mediates cell adhesion via homophilic as well as heterophilic binding to other proteins of the subgroup. Multiple cellular activities have been attributed to the encoded protein, including roles in the differentiation and arrangement of tissue three-dimensional structure, angiogenesis, apoptosis, tumor suppression, metastasis, and the modulation of innate and adaptive immune responses. Multiple transcript variants encoding different isoforms have been reported, but the full-length nature of all variants has not been defined.Specifica
| CEA (CEACAM5) | |
| Monoclonal | |
| 1 mg/mL | |
| PBS with 1% BSA, 50% glycerol and 0.02% sodium azide | |
| P06731 | |
| CEACAM5 | |
| Human recombit protein fragment corresponding to amino acids 35-680 of human CEACAM5 produced in SF9 cell. | |
| 100 μL | |
| Primary | |
| Human | |
| Antibody | |
| IgG2b |
| Immunohistochemistry (Paraffin), Western Blot | |
| OTI1C2 | |
| Unconjugated | |
| CEACAM5 | |
| CD66e, CEA | |
| Mouse | |
| Affinity Chromatography | |
| RUO | |
| 1048 | |
| -20° C, Avoid Freeze/Thaw Cycles | |
| Liquid |
Correzione del contenuto del prodotto
Il programma Encompass di Fisher Scientific offre articoli che non fanno parte del nostro portafoglio di distribuzione. Questi prodotti in genere non hanno immagini o descrizioni dettagliate. Tuttavia, ci impegniamo a migliorare la vostra esperienza di acquisto. Si prega di utilizzare il modulo sottostante per fornire un feedback relativo al contenuto di questo prodotto.
Titolo del prodotto
Individuate un'opportunità di miglioramento?Condividi una correzione di contenuto